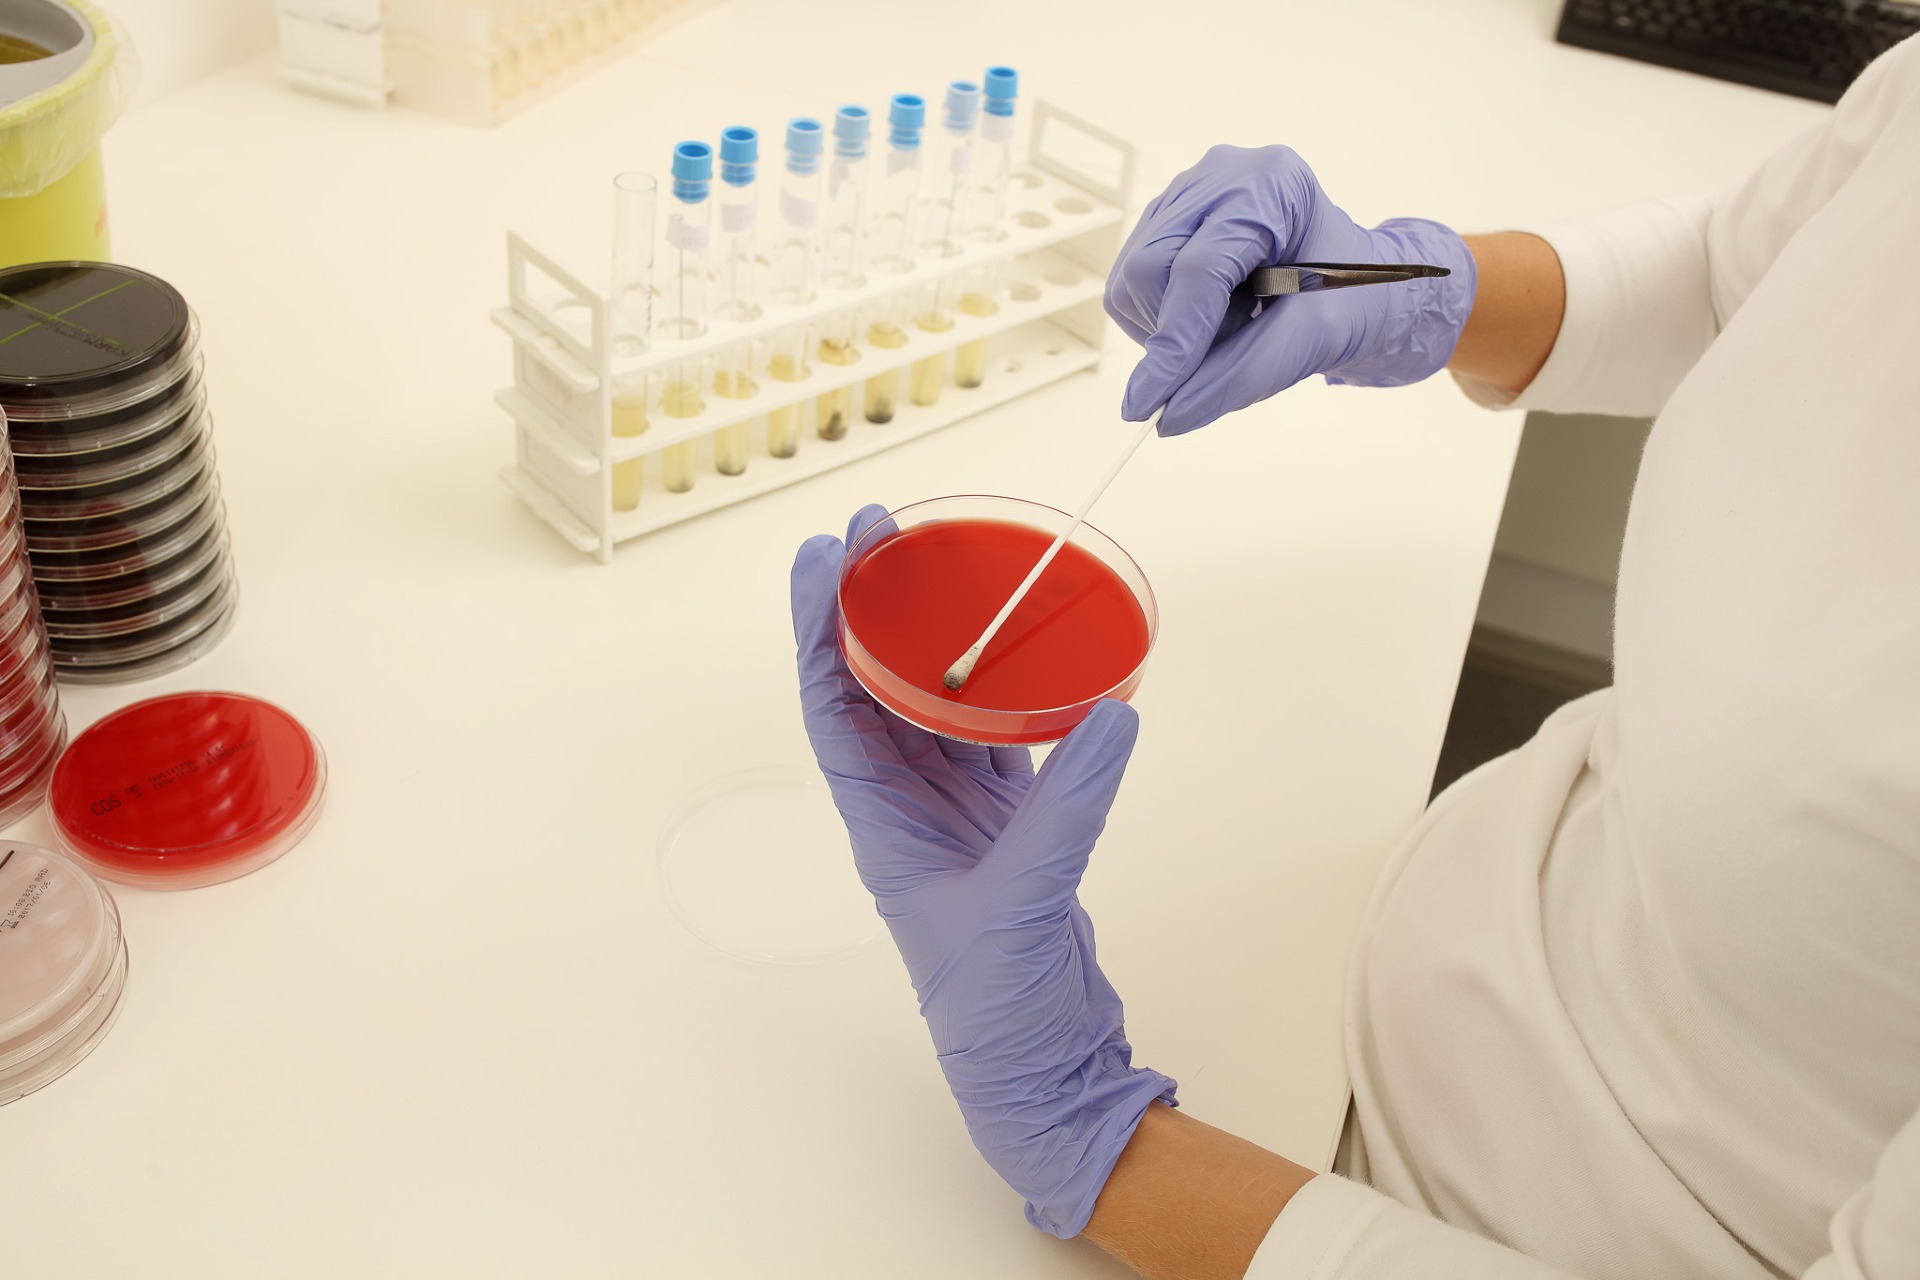

EUC Laboratoře

Zdravotnická skupina EUC provozuje 25 klinik, 11 laboratoří, 13 mamocenter, 26 lékáren, lékárenský e-shop a služby domácí péče.
#EUC
EUC Laboratoře Praha a EUC Laboratoře CGB mají 460 zaměstnanců.
#EUCLaboratoře
Seznamte se s laboratorní jedničkou!
EUC Laboratoře a EUC Laboratoře CGB jsou součástí zdravotnické skupiny EUC, kterou tvoří kromě laboratoří také kliniky, lékárny, mamocentra, prémiová péče Canadian Medical, domácí péče Včelka a Advantis Medical. Laboratoře poskytují diagnostickou činnost v nejrůznějších oborech. Počtem zaměstnanců a dlouholetou praxí se řadí mezi největší pracoviště v České republice. Laboratoře jsou akreditovaným školícím střediskem. Zajišťují služby pro klienty a konzultace v rámci celé ČR, ve speciálních případech i se zahraničními odborníky.
EUC Laboratoře CGB
Ostrava: Laboratoř molekulární genetiky, Laboratoř patologie, Cytogenetická laboratoř
Zlín: Laboratoř patologie
Přerov: Laboratoře patologie (DIMOLab s.r.o.)
EUC Laboratoře Praha
Praha Palackého: Laboratoř biochemie a hematologie
Praha Kartouzská: Laboratoř biochemie
Praha Lisabonská: Centrální příjem, Laboratoř biochemie, Hematologická laboratoř, Laboratoř imunologie a alergologie, Bakteriologická laboratoř, PCR laboratoř
Co nám leží na srdci
Za každým laboratorním vzorkem stojí jeden konkrétní člověk. EUC Laboratoře takto vstupují do osudů statisíců lidí a to je velký závazek. Proto k nám hledáme kolegy, kteří mají zájem o obor, energii a chuť se stále vzdělávat a zlepšovat a záleží jim na tom, jakou práci odvádějí.
Proč je radost u nás pracovat?
Nabízíme práci, kterou budete mít rádi a která vás bude bavit. Budete součástí přátelského kolektivu, který se skládá ze špičkových odborníků. Budeme vás nadále podporovat ve vašem vzdělávání a získáte možnost zapojit se do výzkumných grantových projektů. Náš tým je připraven vás přijmout mezi sebe a zajistit vám plnohodnotné zaškolení.
Počet
zaměstnanců
460
Všechna naše oddělení
- Odběrové místo Bílina
- Odběrové místo Brandýs nad Labem
- Odběrové místo České Budějovice
- Odběrové místo Dobřany
- Odběrové místo Hradec Králové
- Odběrové místo Jablonec nad Nisou
- Odběrové místo Jablunkov
- Odběrové místo Kladno
- Odběrové místo Kolín
- Odběrové místo Králův Dvůr
- Odběrové místo Liberec
- Odběrové místo Litvínov
- Odběrové místo Louny
- Odběrové místo Ostrava
- Odběrové místo Pardubice
- Odběrové místo Plzeň
- Odběrové místo Praha
- Odběrové místo Přelouč
- Odběrové místo Příbram
- Odběrové místo Říčany
- Odběrové místo Slaný
- Odběrové místo Týn nad Vltavou
- Odběrové místo Ústí nad Labem
- Odběrové místo Zlín